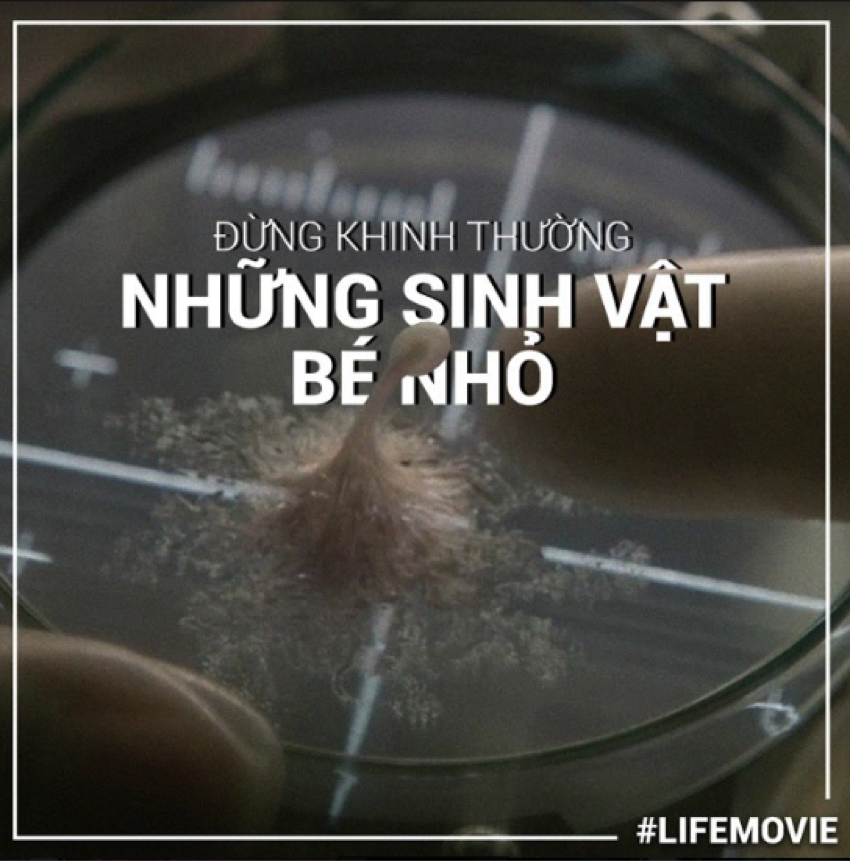

Life kể về câu chuyện của một nhóm các nhà khoa học gồm David Jordan (Jake Gyllenhaal), Miranda North (Rebecca Ferguson), Rory Adams (Ryan Reynolds) thuộc trạm không gian quốc tế tìm được một mẫu vật hữu cơ trên sao Hỏa. Trên đường quay trở về Trái đất, các nhà khoa học quyết định nghiên cứu mẫu vật tìm được ở sao Hỏa (được đặt tên là Calvin) nhằm tìm ra bằng chứng về sự sống ngoài vũ trụ đầu tiên trên thế giới. Từ một dạng sống cơ bản, Calvin tiến hóa có thể tiêu hóa bất cứ vật chất hữu cơ nào, kể cả con người, để sinh tồn. Bị kẹt ngoài vũ trụ bao la, các nhà khoa học buộc phải tìm cách tiêu diệt Calvin trước khi trở về trái đất. Thế nhưng, từng người một lại trở thành miếng mồi cho con quái thú.
Đừng khinh thường những sinh vật bé nhỏ
Không ai nghĩ Calvin nhỏ xíu yếu ớt đó có thể trở nên nguy hiểm. Và với tinh thần cảnh giác ở mức số 0 khi tạo lập những bức “tường lửa” bảo vệ mỏng manh, họ vô tình “thí nghiệm” chính mạng sống của mình. Sự chủ quan của phi hành đoàn đã gây ra hậu quả khôn lường. Để thoát khỏi sự giam cầm của con người, nó buộc phải trỗi dậy, tấn công những kẻ bắt giữ mình. Nếu nó bại trận, hoặc là nó chết, hoặc nó sẽ mãi mãi trở thành vật thí nghiệm
Sinh vật nhỏ bé luôn có sức mạnh tiềm năng đáng gờm.
Cơ thể chống được nhiệt độ cao, lưu trữ được nước và oxi để đề phòng bất trắc, trí thông minh đến mức vượt trội, con quái vật này gần như vượt quá khả năng của con người. Dù cố gắng cách mấy, 6 nhà khoa học vẫn bó tay trước một sinh vật dường như nhỏ bé và vô hại. Khó có thể tưởng tượng được nếu 1 ngày nó có thể đặt chân tới trái đất thì sẽ gây ra sự kinh hoàng đến nhường nào. Và chuyện gì đến cũng đến, từng phi hành gia phải đối mặt với một trận chiến tưởng chừng khó có thể xảy ra, Calvin nuốt chứng mọi thứ để tồn tại.
Hãy cẩn thận với những thứ ta tìm kiếm và đứng bao giờ chủ quan với bất cứ thứ gì

Con người luôn tìm kiếm những điều mới mẻ, nhưng có khi nào tự đặt chất vấn cho bản thân mình “liệu rằng mình có đủ năng lực để ra ngoài không gian, tìm kiếm những điều mới mẻ với một môi trường không thuộc về thế mạnh của con người?”. Câu chuyện của Life đã cho khán giả nhận ra rằng, đừng bao giờ chủ quan, và phải tự lượng sức mình khi tìm kiếm điều mới mẻ dù chỉ là một sinh vật nhỏ bé ngoài sao Hỏa. Cái kết của bộ phim là một lời cảnh tỉnh cho những phi hành đoàn đang tiếp tục đào bới những thứ hay ho ở các hành tinh và luôn một tư tưởng “con người là khôn ngoan và giỏi nhất”

Hãy luôn đặt tinh thần cẩn trọng lên hàng đầu

Và đừng bao giờ chủ quan với những thứ ta chưa hề biết tới
Cuộc chiến sinh tồn buộc có kẻ phải hi sinh
Bắt đầu bằng những tế bào nhỏ xíu vô hại, Calvin (tên của sinh vật ngoài hành tinh) có vẻ là một đứa trẻ thân thiện. Nhưng rồi họ phát hiện ra Calvin cũng có “chiến lược” sinh tồn của nó, đó chính là “ăn thịt” toàn bộ sinh vật sống trên tàu, gấp rút tiến hóa để thích nghi với môi trường. Đó âu cũng là bản năng của mỗi loài. Calvin không xấu, nó chỉ là một sinh vật cố gắng để sống sót trong hoàn cảnh xa lạ. Câu chuyện của Life không cố gắng phân biệt người tốt kẻ xấu mà đơn giản chỉ là cuộc chiến sinh tồn giữa hai giống loài mà thôi. Trong một cuộc chiến sinh tồn tranh giành sự sống, buộc phải có kẻ hi

Đối với khán giả, Life ngoài việc mang đến những yếu tố kinh dị, hồi hộp, trải nghiệm mới lạ về cuộc chiến sinh vật ngoài hành tinh và con người, nó còn là một hồi chuông cảnh tỉnh sâu sắc cho những ai đang quá tự tin về bản thân mình mà khinh thường tất cả những thứ xung quanh, đặc biệt là những đối thủ nhỏ bé nhất.
Trailer chính thức của bộ phim.
Bộ phim hiện đang được khởi chiếu tại các rạp trên toàn quốc.